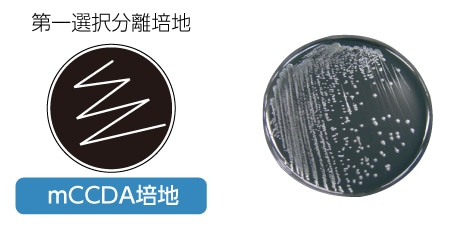

食品微生物検査の手順
(カンピロバクター)
標準試験法(NIHSJ-02)
<試料調製・増菌培養>
検体25gを採取し、100mlのプレストン増菌培地を加え、30秒間ホモジナイズします。
<微好気環境の作り方>
微好気条件下で42℃、24~48時間培養
<選択分離>
増菌後の培養液を油層をできる限り避けて採取し、第一および第二選択分離培地に画線塗抹し培養します。
<判定>
24時間では、カンピロバクター・ジェジュニ/コリの発育は悪いので、48時間培養し、判定します。<純培養>
選択分離培地上に発育した集落のうち、カンピロバクター・ジェジュニ/コリと思われる集落を計5個釣菌し、非選択培地に継代して、37℃で24~48時間微好気培養を行います。<同定>
疑わしい集落を1つ釣菌し、鑑定試験を行います。 ・カタラーゼ試験 ・オキシダーゼ試験 ・菌形の観察迅速法(カンピロバクター属検出キット)
<前処理>
リンス液の場合:検体をBPW400mlでリンスする。肉片検査の場合:検体25gを採取し、225mlのボルトンブロスを加え、ホモジナイズします。

<前培養>
リンス液の場合:50mlの遠沈管にリンス液27mlと倍濃度のボルトンブイヨン(ボルトンブイヨン選択剤と事前に調製)27mlと混合培養します。(微好気環境は不要)肉片検査の場合:ストマッカー袋のまま微好気環境下で培養します。


プログラムは“CA“を選択し、運転します。(所要時間:75分)
PCRチューブを取り出し、Buffer Bを直接4滴入れ、200bを専用カセットのウィンドウに滴下します。
2分後、再度Buffer Bを直接カセットウィンドウに4滴入れます。
1分後に、カセットウィンドウを開け、判定します。
微生物検査を始めたい企業様へ

食品微生物検査キットDDSマスターⅢは、微生物検査に必要な機器を取り揃えた初歩的なキットです。
D(どこでも)、D(誰でも)、S(すぐできる)の名の通り、初めての方でも簡単に微生物検査が行えます。
このセットを使用すれば限られたスペースでも自主検査(微生物検査)がスタートできます。
※DDSキットは5~10検体/日の検体数を目安にしております。
それ以上の検体数や、検査する対象の菌種が多岐にわたる場合、ご相談ください。